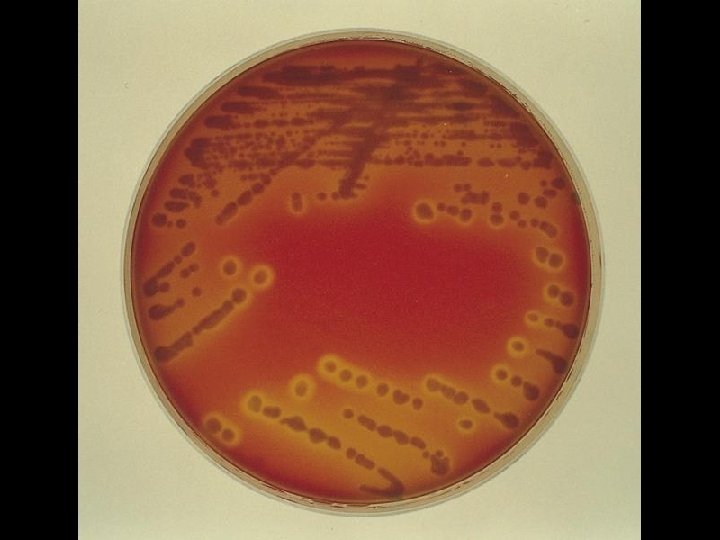

6431d45d55070c642c410ef6c8fd6614.ppt
- Количество слайдов: 57
 Penicillin-resistant pneumococci potentials for modeling Prof. Karl Ekdahl KI/MEB and ECDC
Penicillin-resistant pneumococci potentials for modeling Prof. Karl Ekdahl KI/MEB and ECDC
 About the bug • Streptococcus pneumoniae (pneumococcus) • Gram-positive, encapsulated diplococcus • Capsular swelling observed when reacted with type-specific antisera (Quellung reaction)
About the bug • Streptococcus pneumoniae (pneumococcus) • Gram-positive, encapsulated diplococcus • Capsular swelling observed when reacted with type-specific antisera (Quellung reaction)

 Electron micrograph of pneumococcus Surface capsular polysaccharide
Electron micrograph of pneumococcus Surface capsular polysaccharide
 Polysaccharide capsule • Capsular polysaccharides: hydrophilic gels on organism surface • Most important virulence factor • Protects against phagocytosis by granulocytes and macrophages • Elicits a T-cell–independent (not boostable) immune response
Polysaccharide capsule • Capsular polysaccharides: hydrophilic gels on organism surface • Most important virulence factor • Protects against phagocytosis by granulocytes and macrophages • Elicits a T-cell–independent (not boostable) immune response
Pathogenesis • Colonisation of mucous membranes in respiratory tracts • Adhesion (bacterial adhesins) • Invasion of tissues if not defeated Ø Middle ear Ø Sinuses Ø Bronchi
Pathogenesis • Colonisation of mucous membranes in respiratory tracts • Adhesion (bacterial adhesins) • Invasion of tissues if not defeated Ø Middle ear Ø Sinuses Ø Bronchi
 Important for modelling: Pneumococcal serotypes • Based on properties of capsular polysaccharides • Immunologically distinct and basis for classification Ø > 40 serogroups (e. g. group 19) Ø > 90 serotypes (e. g. types 19 A, 19 C, 19 F) • No immunologic cross-reactivity between serogroups • Some cross-reactivity within some serogroups and some cross-protection • Geographical and temporal variation • Some more immunogenic than others
Important for modelling: Pneumococcal serotypes • Based on properties of capsular polysaccharides • Immunologically distinct and basis for classification Ø > 40 serogroups (e. g. group 19) Ø > 90 serotypes (e. g. types 19 A, 19 C, 19 F) • No immunologic cross-reactivity between serogroups • Some cross-reactivity within some serogroups and some cross-protection • Geographical and temporal variation • Some more immunogenic than others
 IPD serotypes over time (Sweden) % 20 15 10 Type 1 Type 3 Type 4 Type 6 B Type 7 F Type 9 V Type 14 Type 23 F 5 0 1987 1992 1997
IPD serotypes over time (Sweden) % 20 15 10 Type 1 Type 3 Type 4 Type 6 B Type 7 F Type 9 V Type 14 Type 23 F 5 0 1987 1992 1997
 Important for modelling: Pneumococcal serotypes (II) • Children <5 y lack ability to mount antibody response to several serotypes • Such types (6 B, 9 V, 14, 19 F, 23 F) more dominating among young children = child serotypes Ø Account for the majority of carriage and disease in children Ø Explains high incidences of carriage and disease in the youngest • Child serotypes heavily linked to antibiotic resistance • Limited number of very successful international clones
Important for modelling: Pneumococcal serotypes (II) • Children <5 y lack ability to mount antibody response to several serotypes • Such types (6 B, 9 V, 14, 19 F, 23 F) more dominating among young children = child serotypes Ø Account for the majority of carriage and disease in children Ø Explains high incidences of carriage and disease in the youngest • Child serotypes heavily linked to antibiotic resistance • Limited number of very successful international clones
 Pneumococcal vaccine Antibody response in young children
Pneumococcal vaccine Antibody response in young children
 Important for modelling: Capsular switch • Pnc very “promiscous bacteria” with excellent ability to exchange genetic material • Highly capable of switching serotype while retaining other properties (incl antibiotic resistance) • Likely frequent event (DCC outbreaks) • Survival mechanism • Often switches to other “child serotypes”: Ø 23 F 19 F Ø 9 V 14
Important for modelling: Capsular switch • Pnc very “promiscous bacteria” with excellent ability to exchange genetic material • Highly capable of switching serotype while retaining other properties (incl antibiotic resistance) • Likely frequent event (DCC outbreaks) • Survival mechanism • Often switches to other “child serotypes”: Ø 23 F 19 F Ø 9 V 14
 About the disease • A major cause of morbidity and mortality worldwide Ø Over 1 million deaths annually due to pneumonia Ø Causes more deaths in young children in US than any other single microorganism • Incidence of infection varies globally • Age groups at highest risk for disease: Ø Infants and children < 2 years of age Ø Adults > 65 years of age • Pneumococcal disease frequently observed in children up to 5 years of age
About the disease • A major cause of morbidity and mortality worldwide Ø Over 1 million deaths annually due to pneumonia Ø Causes more deaths in young children in US than any other single microorganism • Incidence of infection varies globally • Age groups at highest risk for disease: Ø Infants and children < 2 years of age Ø Adults > 65 years of age • Pneumococcal disease frequently observed in children up to 5 years of age
 Clinical manifestations Meningitis Otits media Pneumonia Sinusitis Pericarditis Endocarditis Septicemia Peritonitis Osteomyelitis Arthritis
Clinical manifestations Meningitis Otits media Pneumonia Sinusitis Pericarditis Endocarditis Septicemia Peritonitis Osteomyelitis Arthritis
 Significant disease burden in children Disease severity Estimated number of cases per year (US) Noninvasive Bacteremia 1, 400 17, 000 Increases Invasive Meningitis 71, 000 Pneumonia 5– 7 million Otitis media Prevalence MMWR. 1997; 46: 1 -24.
Significant disease burden in children Disease severity Estimated number of cases per year (US) Noninvasive Bacteremia 1, 400 17, 000 Increases Invasive Meningitis 71, 000 Pneumonia 5– 7 million Otitis media Prevalence MMWR. 1997; 46: 1 -24.
 Etiology of acute otitis media (South Sweden)
Etiology of acute otitis media (South Sweden)
 Acute otitis media • From colonisation to invasion of middle ear through the eustachian tube • Facilitated by previous viral infection • Mostly in young children with immature immune defence • Day-care centre (DCC) attendance and prior antibiotic treatment are risk factors
Acute otitis media • From colonisation to invasion of middle ear through the eustachian tube • Facilitated by previous viral infection • Mostly in young children with immature immune defence • Day-care centre (DCC) attendance and prior antibiotic treatment are risk factors


 Invasive pneumococcal disease (IPD) • Bacterial growth in normally sterile fluids Ø Ø Ø Blood (pneumonia, meningitis, endocarditis) CSF (meningitis) Joint fluids (artritis) Pleural fluid (pleuritis) Peritoneal fluid (peritonitis)
Invasive pneumococcal disease (IPD) • Bacterial growth in normally sterile fluids Ø Ø Ø Blood (pneumonia, meningitis, endocarditis) CSF (meningitis) Joint fluids (artritis) Pleural fluid (pleuritis) Peritoneal fluid (peritonitis)
 Main clinical picture IPD (South Sweden) Pneumonia 8% CFR Meningitis 18% CFR Septicemia 29% CFR Others 14% CFR
Main clinical picture IPD (South Sweden) Pneumonia 8% CFR Meningitis 18% CFR Septicemia 29% CFR Others 14% CFR


 Age-related incidence of IPD (Europe 2005)
Age-related incidence of IPD (Europe 2005)
 Cases per 100, 000 persons Incidence of invasive pneumococcal disease in children (US 1998) 250 200 150 100 50 0 0– 5 6– 11 12– 17 18– 23 24– 35 36– 47 Age group (months) 48– 59 5– 9 yrs 10– 19 yrs
Cases per 100, 000 persons Incidence of invasive pneumococcal disease in children (US 1998) 250 200 150 100 50 0 0– 5 6– 11 12– 17 18– 23 24– 35 36– 47 Age group (months) 48– 59 5– 9 yrs 10– 19 yrs
 Seasonality IPD (Europe 2005)
Seasonality IPD (Europe 2005)
 Important for modelling: Pneumococcal carriage • Asymptomatic carriage most common pneumococcal manifestation • Nasopharynx of young children most important reservoir of pnc • Ecological niche: carriage of one strain protects aginst carriage of other strains • First week critical: carriage or infection • Colonisations (carriage) is ”protective” of diseas • Younger children carrier for longer time • Distinct seasonality (same as for IPD)
Important for modelling: Pneumococcal carriage • Asymptomatic carriage most common pneumococcal manifestation • Nasopharynx of young children most important reservoir of pnc • Ecological niche: carriage of one strain protects aginst carriage of other strains • First week critical: carriage or infection • Colonisations (carriage) is ”protective” of diseas • Younger children carrier for longer time • Distinct seasonality (same as for IPD)
 Åldersrelaterad bärartid Veckor
Åldersrelaterad bärartid Veckor
 Bärartid av pc-resistenta pneumokocker 28% 12% 6% Vecko r
Bärartid av pc-resistenta pneumokocker 28% 12% 6% Vecko r
 Important for modelling: Role of day care centres (DCC) • 30 -50% of (day care centre) DCC children are carriers during winter months • Rapid spread within DCCs • One dominating serotype in a DCC • Higher rates (same serotype) in siblings to DCC children • Increased risk of IPD Ø 2. 63 -fold risk in children 2– 11 months of age Ø 2. 29 -fold risk in children 12– 23 months of age Ø 3. 28 -fold risk in children 24– 59 months of age Levine OS et al. Pediatrics. 1999; 103: E 28 -E 35.
Important for modelling: Role of day care centres (DCC) • 30 -50% of (day care centre) DCC children are carriers during winter months • Rapid spread within DCCs • One dominating serotype in a DCC • Higher rates (same serotype) in siblings to DCC children • Increased risk of IPD Ø 2. 63 -fold risk in children 2– 11 months of age Ø 2. 29 -fold risk in children 12– 23 months of age Ø 3. 28 -fold risk in children 24– 59 months of age Levine OS et al. Pediatrics. 1999; 103: E 28 -E 35.
 Carriage Rates Group Rate of carriage (%) Preschool children Up to 60 Grammar school children 35 High school students 25 Adults with children in household 18– 29 Adults without children in household 6 Black S, Shinefield H. Pediatr Ann. 1997; 26: 355 -360.
Carriage Rates Group Rate of carriage (%) Preschool children Up to 60 Grammar school children 35 High school students 25 Adults with children in household 18– 29 Adults without children in household 6 Black S, Shinefield H. Pediatr Ann. 1997; 26: 355 -360.
 Antibiotic resistance • Papua New Guinea: First reports of pc resistance in 1969 - Pc resistance >30% already in 1980 • South Africa: First reports of multi-resistance in 1977 - Currently pc resistance ~40% • Alaska: Pc resistance >25% in 1987 • Spain: Pc resistance <7% in 1979 and >46% in 1993
Antibiotic resistance • Papua New Guinea: First reports of pc resistance in 1969 - Pc resistance >30% already in 1980 • South Africa: First reports of multi-resistance in 1977 - Currently pc resistance ~40% • Alaska: Pc resistance >25% in 1987 • Spain: Pc resistance <7% in 1979 and >46% in 1993
 Streptococcus pneumoniae: patterns of penicillin non-susceptibility • Major resistance trends by serotype Ø Most frequently associated non-susceptible serotypes: 6 B, 9 V, 14, 19 A, 19 F, and 23 F • Penicillin-susceptible strains may acquire resistance over time and become resistant to penicillin and other classes of drugs • Non-susceptible serotypes vary geographically over time, by antibiotic usage, and crowding • Non-susceptible strains are often resistant to other classes of antibiotics
Streptococcus pneumoniae: patterns of penicillin non-susceptibility • Major resistance trends by serotype Ø Most frequently associated non-susceptible serotypes: 6 B, 9 V, 14, 19 A, 19 F, and 23 F • Penicillin-susceptible strains may acquire resistance over time and become resistant to penicillin and other classes of drugs • Non-susceptible serotypes vary geographically over time, by antibiotic usage, and crowding • Non-susceptible strains are often resistant to other classes of antibiotics
 Sales of antibiotics in the EU Others* Defined daily dose per 1000 inhabitants per day 40 Macrolides and lincosamides Quinolones 35 Trimethoprim Tetracyclines 30 Cephalosporins 25 Penicillinase-resistant penicillins Narrow-spectrum penicillins 20 Broad- spectrum penicillins 15 10 5 0 F rance Spain P ortugal B elgium Luxem Italy Greece Finland Ireland UK Austria Sweden Germany Netherland Denmark *Includes sulphonamides, penicillinase-resistant penicillins, amphenicols, aminoglycosides, and glycopeptides. Cars O. et al. The Lancet 2001: 357 ; 1851 -2 / Data provided by IMS
Sales of antibiotics in the EU Others* Defined daily dose per 1000 inhabitants per day 40 Macrolides and lincosamides Quinolones 35 Trimethoprim Tetracyclines 30 Cephalosporins 25 Penicillinase-resistant penicillins Narrow-spectrum penicillins 20 Broad- spectrum penicillins 15 10 5 0 F rance Spain P ortugal B elgium Luxem Italy Greece Finland Ireland UK Austria Sweden Germany Netherland Denmark *Includes sulphonamides, penicillinase-resistant penicillins, amphenicols, aminoglycosides, and glycopeptides. Cars O. et al. The Lancet 2001: 357 ; 1851 -2 / Data provided by IMS
 Penicillin-resistant pneumococci MIC (Mg/L) S (susceptible) I (intermediate) R (resistant) Reportable in Sweden <0. 06 0. 12 -1. 0 >2. 0 > 0. 5
Penicillin-resistant pneumococci MIC (Mg/L) S (susceptible) I (intermediate) R (resistant) Reportable in Sweden <0. 06 0. 12 -1. 0 >2. 0 > 0. 5
 Treated episodes of acute otitis media (millions) Antibiotic usage for acute otitis media by age (US) 5 4 3 2 1 0 <1 1 2 3 4 5 6 Age (years) 6 years and older = 16% (~ 4 million) of total episodes of otitis media treated with antibiotics. 7 8 9+ Levin. PDDA. 1997.
Treated episodes of acute otitis media (millions) Antibiotic usage for acute otitis media by age (US) 5 4 3 2 1 0 <1 1 2 3 4 5 6 Age (years) 6 years and older = 16% (~ 4 million) of total episodes of otitis media treated with antibiotics. 7 8 9+ Levin. PDDA. 1997.
 Penicillin-resistant pneumococci (I+R)
Penicillin-resistant pneumococci (I+R)
 Important for modelling: Risk factors for resistance • Low age • DCC attendance (size of DCC group) • Consumption of antibiotics Ø Individual level Ø DCC level Ø Community level
Important for modelling: Risk factors for resistance • Low age • DCC attendance (size of DCC group) • Consumption of antibiotics Ø Individual level Ø DCC level Ø Community level
 Child serotypes and resistance Common in young children Comparative advantage More exposed to antibiotics Resistance
Child serotypes and resistance Common in young children Comparative advantage More exposed to antibiotics Resistance
 Risk factors for PRP-carriage in day-care centres Ab last 6 months Risk ratio TMP/SMX 13. 32 Ampi-/amoxicillin 3. 27 Any antibiotics Cephalosporin 1. 43 3. 14 Erythromycin 1. 38 Pc. V 1. 09 95% C. I. 4. 90 2. 09 1, 78 – 1. 24 – 1. 20 1. 43 1. 01 – 0. 65 – 0. 72 – 2. 63 0. 82 – 1. 45
Risk factors for PRP-carriage in day-care centres Ab last 6 months Risk ratio TMP/SMX 13. 32 Ampi-/amoxicillin 3. 27 Any antibiotics Cephalosporin 1. 43 3. 14 Erythromycin 1. 38 Pc. V 1. 09 95% C. I. 4. 90 2. 09 1, 78 – 1. 24 – 1. 20 1. 43 1. 01 – 0. 65 – 0. 72 – 2. 63 0. 82 – 1. 45
 Penicillin-binding proteins and -lactam resistance
Penicillin-binding proteins and -lactam resistance
 Important for modelling: PRP development (Baquero)
Important for modelling: PRP development (Baquero)
 PRP utveckling (Baquero) Slow introduction phase: Shift towards higher MIC through "selective" antibiotic pressure
PRP utveckling (Baquero) Slow introduction phase: Shift towards higher MIC through "selective" antibiotic pressure
 PRP utveckling (Baquero) Exponential growth phase: Spread of resistant strains independent of antibiotic pressure (though favoured by it)
PRP utveckling (Baquero) Exponential growth phase: Spread of resistant strains independent of antibiotic pressure (though favoured by it)
 PRP utveckling (Baquero) Stationary phase: Resistance ~50%. "Herd immunity" against common serotypes and decreased ability for b-lactams to select for resistance
PRP utveckling (Baquero) Stationary phase: Resistance ~50%. "Herd immunity" against common serotypes and decreased ability for b-lactams to select for resistance
 Spread of international epidemic clones 23 F 23 F 23 F
Spread of international epidemic clones 23 F 23 F 23 F
 Spread of serotype 9 v Southern Sweden 1. Malmö (0195) 2. Staffanstorp (03 -95) 3. Vellinge (03 -95) 4. Landskrona (04 -95) 5. Höganäs (04 -95) 6. Lund (04 -95) 7. Eslöv (04 -95) 5. (17). 10. 4. 13. 14. 7. (18). 8. 12. 11. 6. 2. 1. 15. 3. 9. (19). 16. (20). 8. Kävlinge (06 -95) 9. Trelleborg (08 -95) 10. Helsingborg (08 -95) 11. Burlöv (09 -95) 12. Lomma (10 -95) 13. Höör (12 -95) 14. Svalöv (01 -96) 15. Svedala (02 -96) 16. Skurup (03 -96) 17. Bjuv (--) 18. Hörby (--) 19. Sjöbo (--) 20. Ystad (--)
Spread of serotype 9 v Southern Sweden 1. Malmö (0195) 2. Staffanstorp (03 -95) 3. Vellinge (03 -95) 4. Landskrona (04 -95) 5. Höganäs (04 -95) 6. Lund (04 -95) 7. Eslöv (04 -95) 5. (17). 10. 4. 13. 14. 7. (18). 8. 12. 11. 6. 2. 1. 15. 3. 9. (19). 16. (20). 8. Kävlinge (06 -95) 9. Trelleborg (08 -95) 10. Helsingborg (08 -95) 11. Burlöv (09 -95) 12. Lomma (10 -95) 13. Höör (12 -95) 14. Svalöv (01 -96) 15. Svedala (02 -96) 16. Skurup (03 -96) 17. Bjuv (--) 18. Hörby (--) 19. Sjöbo (--) 20. Ystad (--)
 PRP and antibiotic consumption in children
PRP and antibiotic consumption in children
 Basic reproductive rate for carriage of PRP in DCC (Southern Sweden)
Basic reproductive rate for carriage of PRP in DCC (Southern Sweden)
 Rationale for Vaccination Against Streptococcus pneumoniae • Prevention of life-threatening and prevalent pneumococcal disease • Reduction of disease transmission • Reduction of carriage • Reduction of antibiotic resistance • Retention of antibiotic effectiveness
Rationale for Vaccination Against Streptococcus pneumoniae • Prevention of life-threatening and prevalent pneumococcal disease • Reduction of disease transmission • Reduction of carriage • Reduction of antibiotic resistance • Retention of antibiotic effectiveness
 Old polysaccharide vaccines • T cells-independent immune response Ø Ø Ø Ø Ø No immunological memory No booster response Non-immunogenic in young children 23 of 90 serotypes Protects against invasive disease in adults Questionable protection against pneumonia No protection against otitis media No effect on carriage Commercially available since 1984
Old polysaccharide vaccines • T cells-independent immune response Ø Ø Ø Ø Ø No immunological memory No booster response Non-immunogenic in young children 23 of 90 serotypes Protects against invasive disease in adults Questionable protection against pneumonia No protection against otitis media No effect on carriage Commercially available since 1984
 New protein-conjugated vaccines • • • T cell-dependent immune response Immunological memory Booster response Immunogenic also in young children 7 -11 of 90 serotypes Protects against invasive disease in all age groups (type-specific) • Protects against AOM (type-specific) • Effective against carriage • Licensed in USA February 2000 & European approval February 2001
New protein-conjugated vaccines • • • T cell-dependent immune response Immunological memory Booster response Immunogenic also in young children 7 -11 of 90 serotypes Protects against invasive disease in all age groups (type-specific) • Protects against AOM (type-specific) • Effective against carriage • Licensed in USA February 2000 & European approval February 2001
 Important for modelling: Conjugate vaccine reduction of carriage • • Significant reduction of vaccine types No reduction in non-vaccine types Effect >1 year after vaccination Herd immunity
Important for modelling: Conjugate vaccine reduction of carriage • • Significant reduction of vaccine types No reduction in non-vaccine types Effect >1 year after vaccination Herd immunity
 Important for modelling: Serotype replacement • Seen in both carriage of disease • To a large extent switch to non-vaccin types • Regulated by competition between species Ø Increase in prevalence of serotypes present in population Ø Introduction of ”new” serotypes (previously unable to compete Ø Unmasking of subdominant types in an individual • May result in a switch to more immunogenic types Ø Acquired immunity at an earlier age • Replacement of other bacteria
Important for modelling: Serotype replacement • Seen in both carriage of disease • To a large extent switch to non-vaccin types • Regulated by competition between species Ø Increase in prevalence of serotypes present in population Ø Introduction of ”new” serotypes (previously unable to compete Ø Unmasking of subdominant types in an individual • May result in a switch to more immunogenic types Ø Acquired immunity at an earlier age • Replacement of other bacteria
 Important for modelling: Vaccine effect on antibiotic resistance • Reduction of antibiotics consumption (15 -20% Israel) • Reduction of carriage of antibiotic-resistant bacteria Ø Vaccine types = child serotypes = resistant types • Herd immunity: decreased carriage in siblings • Reduction of infection with antibiotic resistant bacteria • But the bacteria will fight back Ø Serotype replacement to non-vaccine types Ø They will eventually also become resistant
Important for modelling: Vaccine effect on antibiotic resistance • Reduction of antibiotics consumption (15 -20% Israel) • Reduction of carriage of antibiotic-resistant bacteria Ø Vaccine types = child serotypes = resistant types • Herd immunity: decreased carriage in siblings • Reduction of infection with antibiotic resistant bacteria • But the bacteria will fight back Ø Serotype replacement to non-vaccine types Ø They will eventually also become resistant
 Some important questions to be answered by modellers • • What is the relative importance of antibiotic consumption on individual, DCC and community level? Are there differences in ability between antibiotics to select for resistance? Is there a threshold level of community antibotic consumption, critical for the spread of epidemic clones? If so would it be different for different serotypes/clones? Why clonal spread for some pneumo-cocci, but not for others? Is antibiotic resistance reversible in PRP given the importance of clones in the epidemiology? How will the new conjugated vaccines affect the ecology (serotype distribution) in high, medium and low prevalence settings? Are these vaccines the solution to the problem with antibiotic resistance?
Some important questions to be answered by modellers • • What is the relative importance of antibiotic consumption on individual, DCC and community level? Are there differences in ability between antibiotics to select for resistance? Is there a threshold level of community antibotic consumption, critical for the spread of epidemic clones? If so would it be different for different serotypes/clones? Why clonal spread for some pneumo-cocci, but not for others? Is antibiotic resistance reversible in PRP given the importance of clones in the epidemiology? How will the new conjugated vaccines affect the ecology (serotype distribution) in high, medium and low prevalence settings? Are these vaccines the solution to the problem with antibiotic resistance?
 Alternative solution ?
Alternative solution ?


